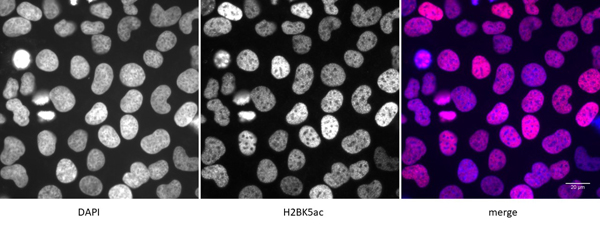
product-image-AAA59834_IF11.jpg

Rabbit Histone H2BK5ac Polyclonal Antibody | anti-H2BK5ac antibody
Histone H2BK5ac antibody (pAb)
DB (Dot Blot)
(Histone H2B acetyl Lys5 pAb tested by dot blot analysis. Dot blot analysis was used to confirm the specificity of Histone H2B acetyl Lys5 pAb for acetyl-Lys5 of histone H2B. Decreasing amounts of modified and unmodified peptides were spotted onto PVDF and probed with the antibody at a dilution of 1:5,000. Lane 1: Peptide acetylated at lysine 5 of H2B. Lane 2: Unmodified lysine 5 peptide. Lane 3: Peptide acetylated at lysine 16 of H2B. Lane 4: Unmodified lysine 16 peptide. Lane 5: Peptide acetylated at lysine 120 of H2B. Lane 6: Unmodified lysine 120 peptide.)
WB (Western Blot)
(Histone H2B acetyl Lys5 pAb tested by Western blot. HeLa acid extract (5 ug per lane) was probed with Histone H2B acetyl Lys5 polyclonal antibody (1:2,000 dilution). Lane 1: No treatment. Lane 2: Cells treated with sodium butyrate. Lane 3: Human recombinant H2B (200 ng).)
IF (Immunofluorescence)
(Detection of H2BK5ac by immunofluorescence. U2OS cells were stained with H2BK5ac antibody at a dilution of 1:500. Left panel: DAPI. Middle panel: H2BK5ac antibody staining. Right panel: merge.)
ChIP (Chromatin Immunoprecipitation)
(Histone H2B acetyl Lys5 pAb tested by ChIP analysis. Chromatin IP performed using the ChIP-IT Express Kit and HeLa Chromatin (1.5 x 106 cell equivalents per ChIP) using 10 ul of Histone H2B acetyl Lys5 pAb or the equivalent amount of rabbit IgG as a negative control. Real time, quantitative PCR (RT-qPCR) was performed on DNA purified from each of the ChIP reactions using a primer pair specific for the indicated gene. Data are presented as Fold Enrichment of the ChIP antibody signal versus the negative control IgG using the ddCT method.)
ChIP (Chromatin Immunoprecipitation)
(Histone H2B acetyl Lys5 pAb tested by ChIP-Seq. ChIP was performed using chromatin from the H1 human embryonic stem cell line. ChIP DNA was sequenced on the Illumina GA II and sequence tags were mapped to identify H2BK5Ac binding. The image shows H2BK5Ac binding across a 1 MB region on chromosome 1.)
Background: Histone H2B is one of the core components of the nucleosome. The nucleosome is the smallest subunit of chromatin and consists of 147 base pairs of DNA wrapped around an octamer of core histone proteins (two each of Histone H2A, Histone H2B, Histone H3 and Histone H4). Histone H1 is a linker histone, present at the interface between the nucleosome core and DNA entry/exit points; it is responsible for establishing higher-order chromatin structure. Chromatin is subject to a variety of chemical modifications, including post-translational modifications of the histone proteins and the methylation of cytosine residues in the DNA. Reported histone modifications include acetylation, methylation, phosphorylation, ubiquitylation, glycosylation, ADP-ribosylation, carbonylation and SUMOylation; they play a major role in regulating gene expression. Lysine N-epsilon-acetylation is a dynamic, reversible and tightly regulated protein and histone modification that plays a major role in chromatin remodeling and in the regulation of gene expression in various cellular functions. Histone H2A and Histone H2B are acetylated in bulk chromatin by p300 and form acetylated Histone H2A/Histone H2B heterodimers. When DNA associates with intact core histone octamers that contain acetylated H2A/H2B dimers, the inhibition of transcriptional initiation significantly decreases, indicating that acetylation of their lysine residues may mediate transcription.
NCBI and Uniprot Product Information
Customer Reviews
Loading reviews...
Share Your Experience
Similar Products
Product Notes
The H2BK5ac (Catalog #AAA59834) is an Antibody produced from Rabbit and is intended for research purposes only. The product is available for immediate purchase. The Histone H2BK5ac antibody (pAb) reacts with Human, Wide Range Predicted and may cross-react with other species as described in the data sheet. AAA Biotech's Histone H2BK5ac can be used in a range of immunoassay formats including, but not limited to, WB (Western Blot), IF (Immunofluorescence), DB (Dot Blot), ChIP (Chromatin immunoprecipitation), ChIP (Chromatin immunoprecipitation). Researchers should empirically determine the suitability of the H2BK5ac for an application not listed in the data sheet. Researchers commonly develop new applications and it is an integral, important part of the investigative research process. It is sometimes possible for the material contained within the vial of "Histone H2BK5ac, Polyclonal Antibody" to become dispersed throughout the inside of the vial, particularly around the seal of said vial, during shipment and storage. We always suggest centrifuging these vials to consolidate all of the liquid away from the lid and to the bottom of the vial prior to opening. Please be advised that certain products may require dry ice for shipping and that, if this is the case, an additional dry ice fee may also be required.Precautions
All products in the AAA Biotech catalog are strictly for research-use only, and are absolutely not suitable for use in any sort of medical, therapeutic, prophylactic, in-vivo, or diagnostic capacity. By purchasing a product from AAA Biotech, you are explicitly certifying that said products will be properly tested and used in line with industry standard. AAA Biotech and its authorized distribution partners reserve the right to refuse to fulfill any order if we have any indication that a purchaser may be intending to use a product outside of our accepted criteria.Disclaimer
Though we do strive to guarantee the information represented in this datasheet, AAA Biotech cannot be held responsible for any oversights or imprecisions. AAA Biotech reserves the right to adjust any aspect of this datasheet at any time and without notice. It is the responsibility of the customer to inform AAA Biotech of any product performance issues observed or experienced within 30 days of receipt of said product. To see additional details on this or any of our other policies, please see our Terms & Conditions page.Item has been added to Shopping Cart
If you are ready to order, navigate to Shopping Cart and get ready to checkout.